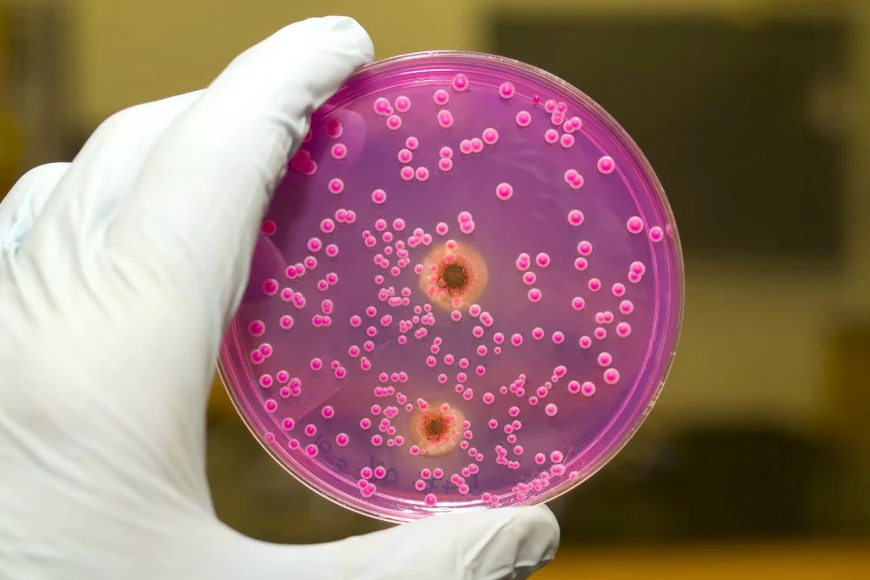
Candida Test for Diabetics: Risk and Testing

Candida Test for Diabetics: Risk and Testing
Understand the importance of Candida testing for diabetics. Detect yeast overgrowth early to protect gut health, immunity, and prevent complications.
Why Diabetics Are at Risk
High blood sugar creates an environment that encourages Candida growth. Combined with immune system challenges, this can lead to recurrent yeast infections, digestive issues, and fatigue. Early Candida screening is essential to prevent long-term health issues.
Common Symptoms in Diabetics
Diabetics may experience symptoms such as oral thrush, vaginal yeast infections, digestive discomfort, bloating, fatigue, and skin rashes. These indicators suggest that a Candida test could be necessary for accurate diagnosis.
Testing Methods for Diabetic Patients
Testing options include blood, stool, urine, and saliva tests. Lab-based tests provide reliable results and help identify the severity and type of yeast overgrowth. Home testing kits are convenient but should be confirmed by professional evaluation.
Benefits of Early Detection
Early detection through a Candida test allows diabetics to manage yeast overgrowth effectively. Timely intervention improves gut health, strengthens immunity, reduces recurring infections, and supports blood sugar management.
Prevention and Care
Managing Candida involves dietary adjustments, probiotics, antifungal treatments, and lifestyle changes. Reducing sugar intake, maintaining hydration, and monitoring gut health are key strategies for diabetics.
Conclusion
A Candida test for diabetics is critical for early detection of yeast overgrowth. Combining testing, professional guidance, and lifestyle management helps maintain gut health, prevent infections, and support overall well-being










